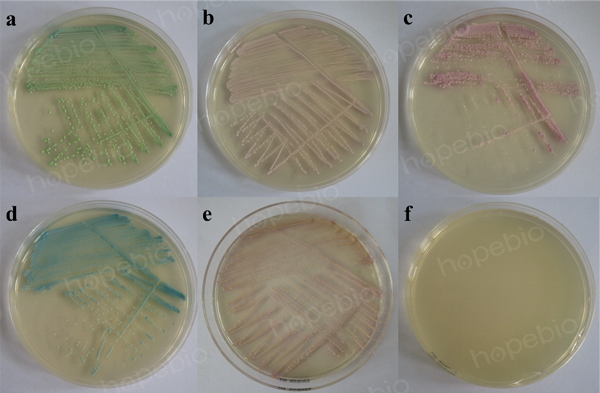

海博微信公众号
海博微信公众号
 海博天猫旗舰店
海博天猫旗舰店


 海博微信公众号
海博微信公众号
 海博天猫旗舰店
海博天猫旗舰店




一、用途及试验原理:
用于快速鉴别念珠菌。根据酶底物法,通过显色区别不同念珠菌,25-30℃培养48小时,白色念珠菌显绿色,热带念珠菌显蓝灰色,光滑念珠菌显淡紫色至紫色,克柔假丝酵母显紫粉色,其他念珠菌显白色,细菌被抑制。
二、培养基配方(g/L):
|
营养物质(蛋白胨等) |
30.0 |
|
色素 |
3.4 |
|
氯霉素 |
0.1 |
|
琼脂 |
15.0 |
|
pH 6.0±0.2 25℃ |
|
三、试验方法:
1. 称取本品9.7g(可按4.85g/100ml的比例扩大或缩小),加入200ml蒸馏水或纯化水中,加热溶解并不停搅拌,煮沸不要超过1分钟。将加热后的培养基水浴冷却至45-50℃,轻轻地摇匀,倾入无菌平皿,备用
2. 制备好的平板保存于2-8℃,应避免光线直接照射。干燥培养基应放置于阴暗干燥处,室温保存。
3. 使用前,把制备好的平板放置室温10-20分钟。
4. 制备质控菌液
5. 取一环质控菌液划线接种到念珠菌显色培养基上。
6. 25-30℃倒置培养基培养48-72小时,记录实验结果。
四、结果观察与解释
接种以下质控菌株,25-30℃倒置培养基培养48-72小时:
|
质控菌株 |
菌株编号 |
生长情况 |
其他特征 |
|
白色念珠菌 |
CMCC(F)98001 |
+++ |
绿色菌落 |
|
热带念珠菌 |
/ |
+++ |
蓝灰色菌落 |
|
克柔氏假丝酵母菌 |
/ |
+++ |
紫红色菌落 |
|
光滑念珠菌 |
/ |
+++ |
淡紫色至紫色菌落 |
|
其他念珠菌 |
/ |
+++ |
白色菌落 |
|
大肠埃希氏菌 |
ATCC25922 |
- |
/ |
图1念珠菌显色培养基微生物质控结果
备注:a:白色念珠菌,b:光滑念珠菌,c:克柔氏假丝酵母菌,d:热带念珠菌,e:酵母菌,f:大肠埃希氏菌
相关产品:
注:本文属海博生物原创,未经允许不得转载。
| 相关文章: | ||



